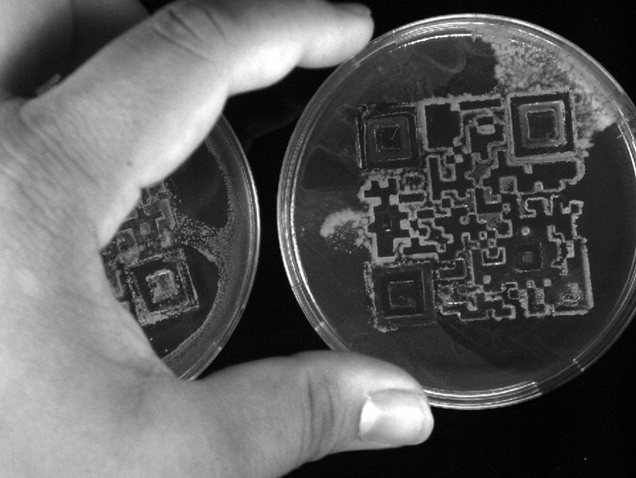
Kilachand Photo Contest Honorable Mention Photograph 1

PhD student Quan Do, while working at the Hasselmo Lab at the Rajen Kilachand Center, carefully inserted a fiber optic cannula into the brain of a rat to provide laser stimulation to a precise neural region. The cannula, unfortunately, missed the target area—and yet, the image that Do captured of this failed attempt was, he thought, aesthetically quite striking. Apparently his fellow scientists at the Kilachand Center agreed.
At a recent “Fall Festival” social event, the Kilachand Center hosted its first annual Research Photo Contest. Members of the Center community in attendance voted live at the event for their favorite submitted photos, and the winner and runners-up were announced as the festival concluded. Quan Do took home first prize for his image of the errant cannula in a sagittal cross-section of a rat brain stained vibrant purple using a DNA stain called DAPI. Other submissions ranged from bacteria resembling a swirl of white-green ocean currents as they undergo changes in membrane potential, to a single, green-illuminated neuron that has been transplanted from the brain of one songbird into the brain of another.
First Place Winner

Quan Do
Graduate Student at The Hasselmo Lab
Blue Light Missing the ‘Blue Spot’; Sagittal cross-section of a rat brain stained vibrant purple using DAPI; shows fiber optic cannula implant for laser stimulation that did not find its way to the Locus Coeruleus
Second Place Winner

Naomi Shvedov
This single neuron (green) in a bird brain, was originally from a different bird yet has matured and formed synapses within the brain of its new host. After transplantation, the neuron migrated from the graft site, matured, and now highlights the remarkable capacity for adult neurogenesis in songbirds. Captured with fluorescence confocal microscopy, this image showcases an immunohistochemically – processed brain slice several weeks after the bird received its brain graft and offers insights into the regenerative capacity of the adult brain
Third Place Winners

Emily Davis
Graduate Student at The Chen Lab
A photo of a single dermal fibroblast cell stained for nuclei (blue) and actin cytoskeleton (phalloidin) in red

Negar Rhamani
PhD Student at The Ho Lab
A section of the hippocampus, an important part of the brain for learning and memory; it was taken using a confocal fluorescence microscope, which makes different proteins and cells glow in various colors; Reelin (a protein that helps braincells communicate) is shown in purple, active brain cells (marked by c-fos) are in red, and memory cells (called engram cells) are in green; the blue color highlights the nuclei, or control centers, of all cells; the green memory cells and purple Reelin cells are both found in a region called CA1, a key area for memory processing
Honorable Mentions
Dev Bhatt
PhD Student at
Luminescent e. Coli colonies growing in a QR code mold. As the cells grow their colonies will fill in the whitespace of the design, allowing for the QR code to be read under the right conditions. This view shows the plate after an overnight of incubation flanked by another plate fabricated via stamping. The white dots on the plate are the e. Coli colonies as they grow and combine.
Odysseas Morgan
Research Technician at
Doing my pipetting with my good friends Mr. Serological and Sir Bunsen

Maya Kostman
PhD Student at
Bacteria undergoing changes in membrane potential

Chris Kuffner
PhD Student at
Here, single RNA molecules in a cell are visible as individual spots. The cell is viewed from above with RNA molecules color-coded by depth, such that RNA at the bottom of the cell are red and RNA at the top are blue. This image was obtained through confocal microscopy of fluorescent signal from a protein that was engineered at BU to only produce signal when bound to a target RNA. This engineered function reduces background signal, enabling clear display of single RNA molecules.
Heloise LeBlanc
PhD Student at
The interface of tumor cells (green), astrocytes (red), and neurons (blue) in the prefrontal cortex of a mouse brain. This picture is from a project investigating how glioblastoma affects normal neuron-astrocyte communication and function near and far from the tumor.

Robert Ovalle Jr.
PhD Student at
Bioluminescent E. coli streaked on an agar plate, spelling el MIG (el Microbial Integration Group).


